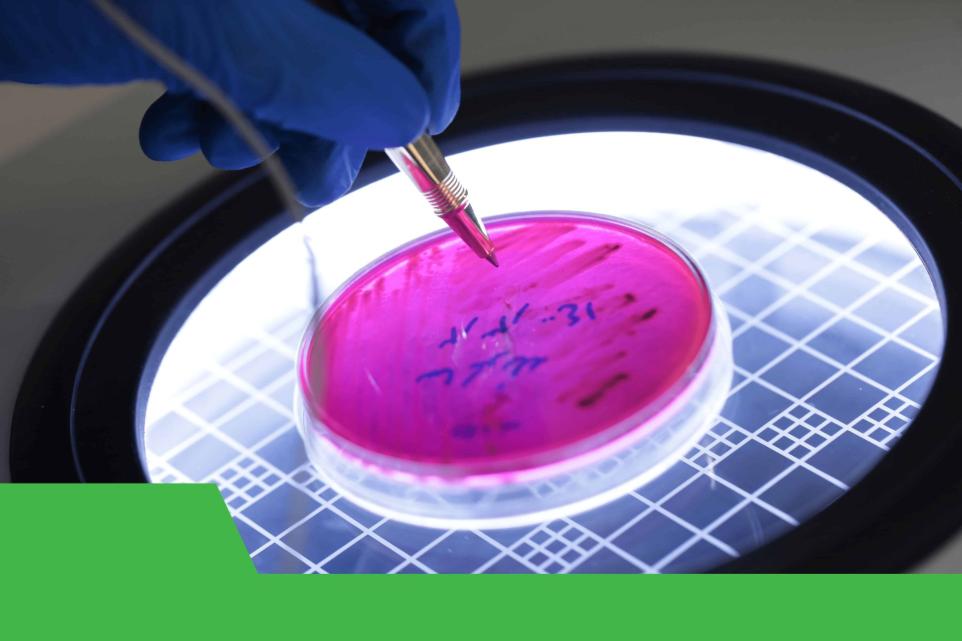

معرفی آزمایشگاه
شرکت پیشگام دامپرور سپاهان با هدف " تغذیه بهتر، زندگی سالمتر" در سال ۱۳۹۴ در اصفهان تاسیس گردید. با همین رویکرد آزمایشگاه فعالیت خود را با بکارگیری کارشناسان مجرب و با فراهم آوردن تجهیزات و فنآوریهای به روز بر اساس استانداردهای جهانی در زمینه مواد غذایی، دامپزشکی و آب و پساب آغاز نمود.
این مجموعه از چهار بخش مجزا تشکیل گریده است:
- آزمایشگاه شیمی تغذیه دام و طیور
- آزمایشگاه میکروبیولوژی
- آزمایشگاه آنالیز دستگاهی
- آزمایشگاه تحقیق و توسعه
آزمایشات با بهرهگیری از آخرین روشهای آنالیز بر اساس استانداردهای ملی و بین المللی ( سازمان دامپزشکی، موسسه استاندارد ایران و معاونت غذا و داروی وزارت بهداشت درمان و آموزش پزشکی کشور WHO) AOAC ASTM، Methods Standard صورت میپذیرد. همچنین جهت بروز رسانی دانش فردی کارشناسان آزمایشگاه در کنگره، همایش و برنامههای آموزشی مرتبط با حوزه فعالیت پیشگام شرکت مینمایند. بصورت دورهای عملیات کنترل کیفی توسط واحد تضمین کیفیت انجام میگردد. همچنین نتایج آزمونهای درخواستی در کمترین زمان و با دقت و صحت بالا به متقاضیان محترم ارائه میشود.
ما استقرار نظام کیفیت را حرکتی ارزشمند در مسیر مشتری مداری دانسته و در این راستا موفق به اخذ گواهینامههای ذیل گردیدهایم:
- اخذ گواهینامه ISO/IEC ۱۷۰۲۵ از سازمان ملی استاندارد
- تاییدیه آزماشگاه همکار اداره کل استاندارد
- عضویت در شبکه راهبردی فناوری
خط مشی آزمایشگاه پیشگام دامپرور سپاهان
آزمایشگاه پیشگام دامپرور سپاهان سیستم مدیریت خود را براساس استاندارد ملی ایران ISO/IEC ۱۷۰۲۵ تجدید نظر دوم پیاده سازی نموده و خط مشی خود را به شرح زیر اعلام و خود را نسبت به توسعه، اجرا و بهبود مداوم اثربخشی آن متعهد میداند:
- افزایش رضایت مشتری، به عنوان اصلیترین عامل در نحوه اجرای فعالیتهای آزمایشگاه
- ارتباط مناسب با آزمایشگاههای همکار
- گسترش کمی و کیفی دامنه شمول آزمونها در محدوده تائید صلاحیت
- ارتقای سطح علمی، دانش فنی و انگیزش کارکنان آزمایشگاه از طریق ارئه آموزش موثر و مداوم
- انجام آزمونهای مطابق دامنه صلاحیت تعیین شده توسط مرکز ملی تایید صلاحیت ایران براساس استانداردهای ملی و بین المللی به روز براساس نیازمندیهای مشتری در کوتاهترین زمان
- رعایت بیطرفی و محرمانگی و پذیرش مسئولیتهای بیطرفی در اجرای عملیات آزمایشگاهی
- اطمینان از استواری عملیات آزمایشگاهی
- اطمینان از درک و اجرای صحیح سیستم مدیریت آزمایشگاه توسط کارکنان
اهداف آزمایشگاه
- افزایش رضایت مشتری، به عنوان اصلیترین عامل در نحوه اجرای فعالیتهای آزمایشگاه
- ارتقاء سطح علمی، دانش فنی و انگیزش کارکنان آزمایشگاه از طریق ارائه آموزش موثر و مستمر
- بکارگیری پیشرفتهترین تجهیزات و دستگاههای مربوط به آنالیز خوراک دام و طیور
خدمات آزمایشگاه
ارائه خدمات مشاوره در خصوص انالیز خوراک دام و طیور
همکاری در پروژههای تحقیقاتی و دانشگاهی
ارائه نتایج در سریعترین زمان با دقت بالا
آنالیز شیمیایی و میکروبی مواد غذایی
حوزه فعالیت آزمایشگاهی
آزمایشگاه دامپزشکی
آزمایشگاه آب و پساب
آزمایشگاه مواد غذایی
آزمایشگاه دامپزشکی
مهمترین هدف در این بخش ارائه نتایج با ضریب اطمینان بالا براساس جدیدترین متد روز میباشد. آنالیز شیمیایی و میکروبی و دستگاهی خوراک دام، طیور و آبزیان از فعالیتهای این بخش میباشد که به شرح زیر است :
آزمایشگاه آب و پساب
آزمایشهای قابل آنالیز در این بخش برگرفته از منابع معتبر داخلی و بین المللی شامل الزامات سازمان ملی استاندارد، شرکتهای مهندسین مشاور آب و پساب، کلیه کارخانهها و صنایع و ... طراحی و راه اندازی شده است.
عمده فعالیت به شرح زیر است:
- مطالعه کمی و کیفی آلودگی منابع آبهای سطحی، زیرزمینی، دریاچهها و طرحهای انتقال آب
- بررسی کیفیت آب مصرفی در کارخانجات، باغات، مراکز نگهداری دام و طیور

آزمایشگاه کنترل مواد غذایی
در این بخش آزمایشهای میکروبی و شیمیایی برروی مواد غذایی مورد مصرف انسان و خوراک دام و طیور و آبزیان صورت میپذیرد. آزمایشهای کنترل مواد غذایی بر مبنای درخواست کارخانجات تولید کننده، وارد کنندهها و صادر کنندهها، دانشگاههای علوم پزشکی، سازمان ملی استاندارد و سایر موسسات و صنایع که مایل به کنترل مواد غذایی مورد مصرف کارکنان خود میباشند، طراحی و راه اندازی شده است.
آزمایشگاه تحقیق و توسعه
این بخش با بهرهگیری از دانش اساتید و متخصصین آزمایشگاهی مجرب در زمینههای تخصصی تغذیه دام و طیور، شیمی آلی، شیمی تجزیه و میکروبیولوژی اهداف زیر را دنبال میکند:
- شناسایی نیازها و چالشهای روز صنعت دام و طیور
- ارائه راهکارها و تولید محصولات جدید
- ارائه مقالات علمی در کنفرانسها و مجلات معتبر داخلی و بین المللی














